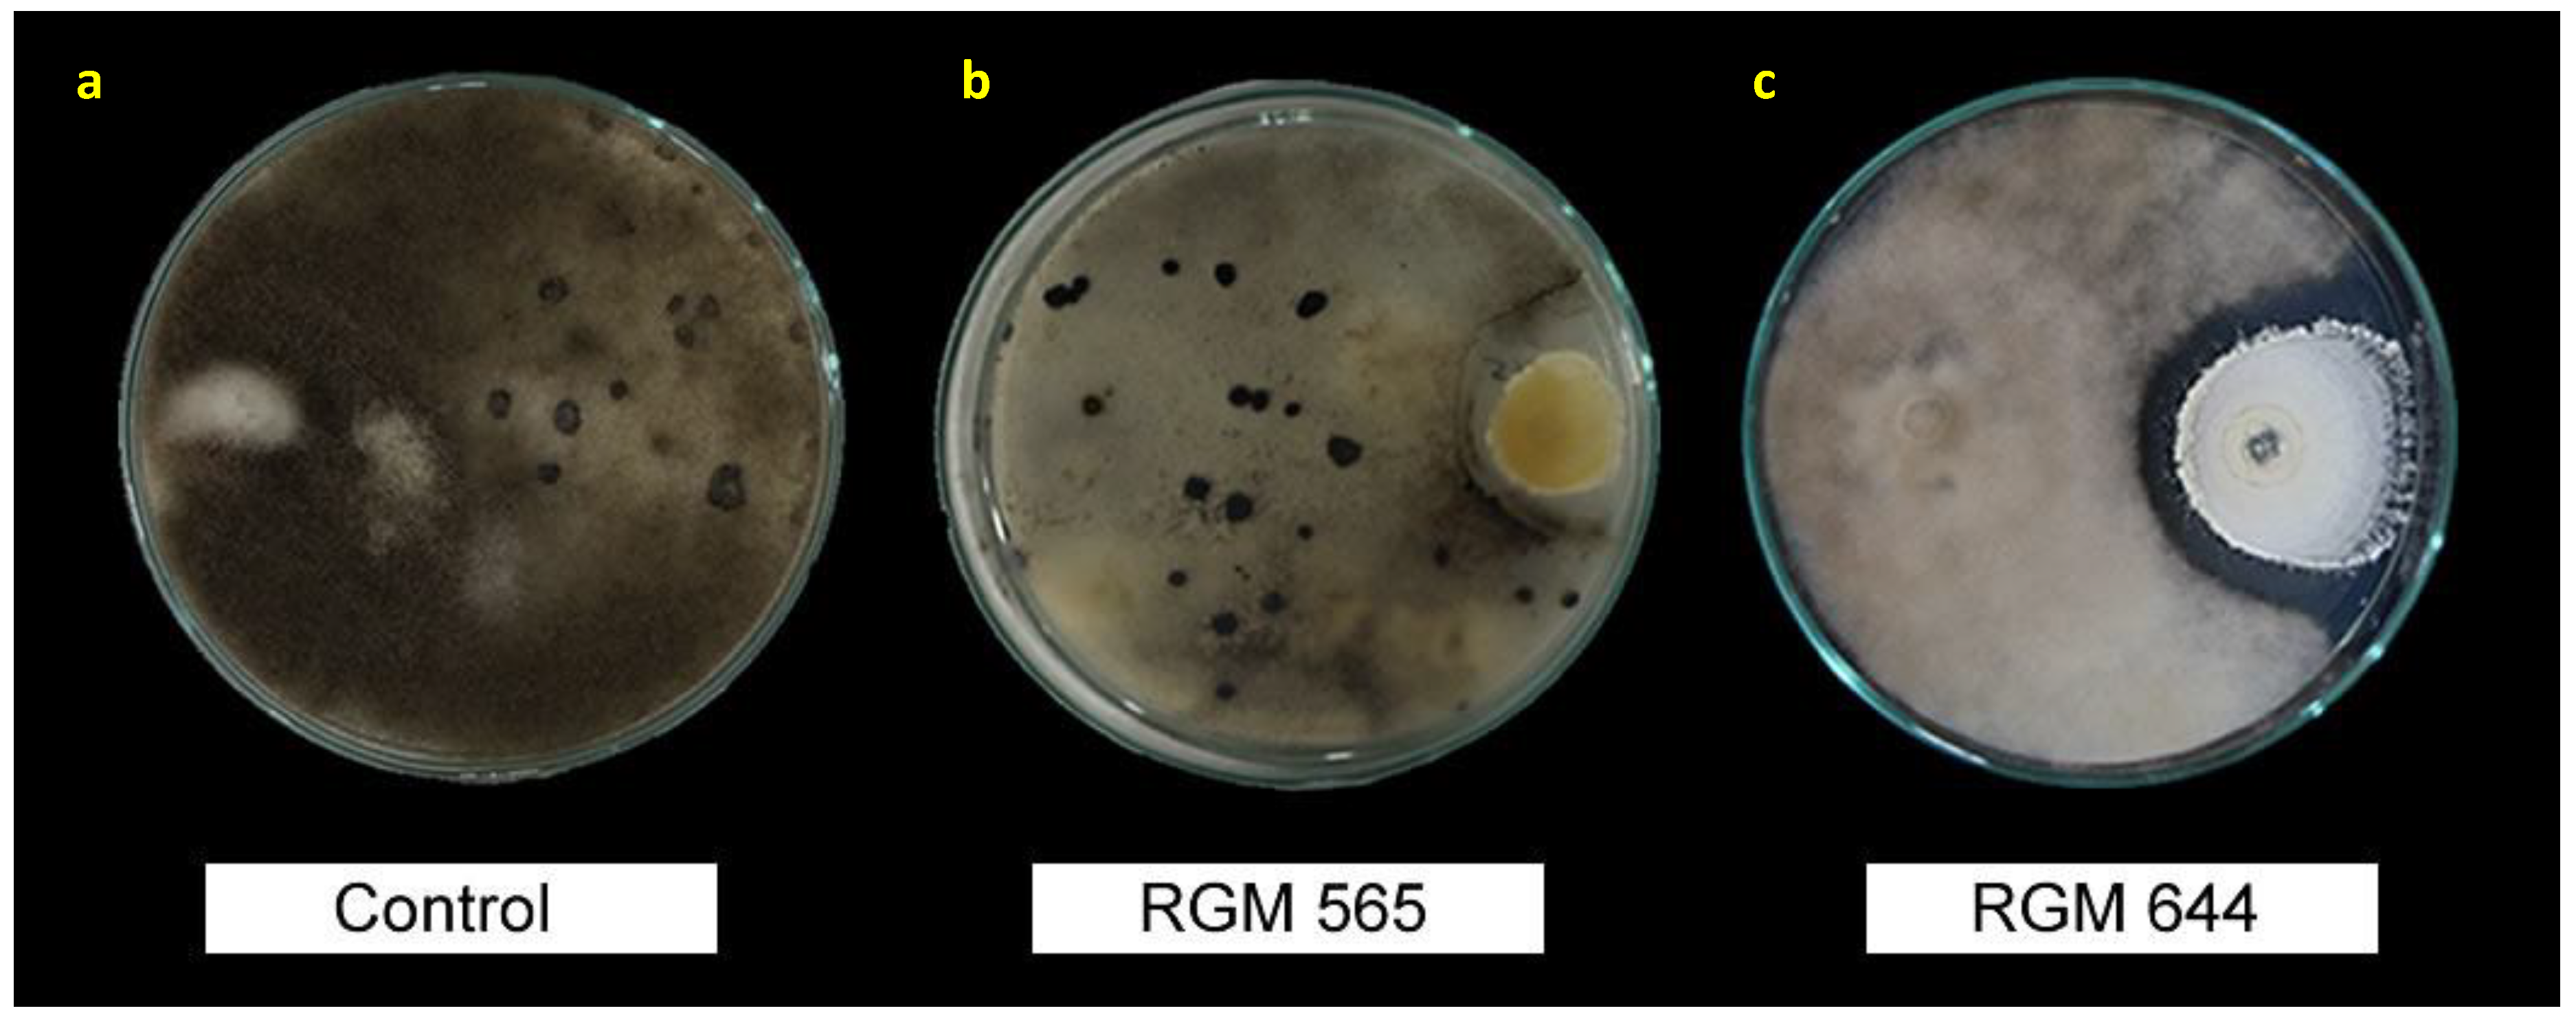
Microorganisms 08 00065 g003 Microorganisms 08 00065 g003

Antifungal Activity of Beauveria bassiana Endophyte against Botrytis cinerea in Two Solanaceae Crops
Abstract
1. Introduction
2. Materials and Methods
2.1. Source of Fungal Strains and Seed
2.2. Surface Seed Disinfection
2.3. Plant Inoculation with B. bassiana Strains and Endophytic Colonization
2.4. Assessment of Endophytic Colonization
2.5. Morphological and Molecular Identification of Reisolate Strain
2.6. In Vitro Antifungal Activity of Endophytic B. bassiana
2.7. Evaluation of Antifungal Activity in the Host Plant
2.8. Statistical Analyses
3. Results
3.1. Endophytic Colonization of B. bassiana Strains in Tomato and Chili Pepper Plants
3.2. In Vitro Growth Inhibition of the Pathogen
3.3. Antifungal Activity in the Host Plant
4. Discussion
4.1. Endophytic Colonization of Beauveria bassiana Strains
4.2. In Vitro Growth Inhibition of the Pathogen Botrytis cinerea
4.3. Antifungal Activity in the Host Plant against Botrytis cinerea
5. Conclusions
Author Contributions
Funding
Acknowledgments
Conflicts of Interest
References
- Punja, Z.K.; Rodriguez, G.; Tirajoh, A. Effects of Bacillus Subtilis strain QST 713 and storage temperatures on post-harvest disease development on greenhouse tomatoes. Crop Prot. 2016, 84, 98–104. [Google Scholar] [CrossRef]
- Williamson, B.; Tudzynski, B.; Tudzynski, P.; van Kan, J.A. Botrytis Cinerea: The cause of grey mould disease. Mol. Plant Pathol. 2007, 8, 561–580. [Google Scholar] [CrossRef] [PubMed]
- Droby, S.; Lichter, A. Post-harvest Botrytis infection: Etiology, development and management. In Botrytis: Biology, Pathology and Control; Springer: Berlin/Heidelberg, Germany, 2007; pp. 349–367. [Google Scholar]
- Carisse, O.; Tremblay, D.-M.; Jobin, T.; Walker, A.S. Disease decision support systems: Their impact on disease management and durability of fungicide effectiveness. Fungicides 2010, 177–200. [Google Scholar] [CrossRef]
- Kaonga, C.C.; Chidya, R.C.G.; Kosamu, I.B.M.; Abdel-Dayem, S.M.; Mapoma, H.W.T.; Thole, B.; Mbewe, R.; Sakugawa, H. Trends in usage of selected fungicides in Japan between 1962 and 2014: A Review. Int. J. Environ. Sci. Technol. 2018, 15, 1801–1814. [Google Scholar] [CrossRef]
- Leroux, P.; Gredt, M.; Leroch, M.; Walker, A.-S. Exploring mechanisms of resistance to respiratory inhibitors in field strains of Botrytis cinerea, the causal agent of gray mold. Appl. Environ. Microbiol. 2010, 76, 6615–6630. [Google Scholar] [CrossRef]
- Bailey, K.L.; Boyetchko, S.M.; Längle, T. Social and economic drivers shaping the future of biological control: A canadian perspective on the factors affecting the development and use of microbial biopesticides. Biol. Control 2010, 52, 221–229. [Google Scholar] [CrossRef]
- Glare, T.; Caradus, J.; Gelernter, W.; Jackson, T.; Keyhani, N.; Köhl, J.; Marrone, P.; Morin, L.; Stewart, A. Have Biopesticides come of age? Trends Biotechnol. 2012, 30, 250–258. [Google Scholar] [CrossRef]
- Lozano-Tovar, M.D.; Ortiz-Urquiza, A.; Garrido-Jurado, I.; Trapero-Casas, A.; Quesada-Moraga, E. Assessment of entomopathogenic fungi and their extracts against a soil-dwelling pest and soil-borne pathogens of olive. Biol. Control 2013, 67, 409–420. [Google Scholar] [CrossRef]
- Lozano-Tovar, M.D.; Garrido-Jurado, I.; Quesada-Moraga, E.; Raya-Ortega, M.C.; Trapero-Casas, A. Metarhizium brunneum and Beauveria Bassiana release secondary metabolites with antagonistic activity against Verticillium Dahliae and Phytophthora Megasperma olive pathogens. Crop Prot. 2017, 100, 186–195. [Google Scholar] [CrossRef]
- Bascom-Slack, C.A.; Arnold, A.E.; Strobel, S.A. Student-directed discovery of the plant microbiome and its products. Science 2012, 338, 485–486. [Google Scholar] [CrossRef]
- Hallmann, J.; Quadt-Hallmann, A.; Mahaffee, W.F.; Kloepper, J.W. Bacterial endophytes in agricultural crops. Can. J. Microbiol. 1997, 43, 895–914. [Google Scholar] [CrossRef]
- Arnold, A.E.; Maynard, Z.; Gilbert, G.S.; Coley, P.D.; Kursar, T.A. Are tropical fungal endophytes hyperdiverse? Ecol. Lett. 2000, 3, 267–274. [Google Scholar] [CrossRef]
- Aly, A.H.; Debbab, A.; Kjer, J.; Proksch, P. Fungal endophytes from higher plants: A prolific source of phytochemicals and other bioactive natural products. Fungal Divers. 2010, 41, 1–16. [Google Scholar] [CrossRef]
- Quesada-Moraga, E.; Munoz-Ledesma, F.J.; Santiago-Alvarez, C. Systemic protection of Papaver Somniferum L. against Iraella Luteipes (Hymenoptera: Cynipidae) by an endophytic strain of Beauveria Bassiana (Ascomycota: Hypocreales). Environ. Entomol. 2009, 38, 723–730. [Google Scholar] [CrossRef] [PubMed]
- Ownley, B.H.; Gwinn, K.D.; Vega, F.E. Endophytic fungal entomopathogens with activity against plant pathogens: Ecology and evolution. BioControl 2010, 55, 113–128. [Google Scholar] [CrossRef]
- Kauppinen, M.; Saikkonen, K.; Helander, M.; Pirttilä, A.M.; Wäli, P.R. Epichloë grass endophytes in sustainable agriculture. Nat. Plants 2016, 2, 15224. [Google Scholar] [CrossRef]
- Arnold, A.E.; Mejía, L.C.; Kyllo, D.; Rojas, E.I.; Maynard, Z.; Robbins, N.; Herre, E.A. Fungal endophytes limit pathogen damage in a tropical tree. Proc. Natl. Acad. Sci. USA 2003, 100, 15649–15654. [Google Scholar] [CrossRef]
- Arnold, A.E.; Lewis, L.C. Ecology and Evolution of Fungal Endophytes, and Their Roles against Insects. Insect-Fungal Associations: Ecology and Evolution; Oxford University Press: New York, NY, USA, 2005; pp. 74–96. [Google Scholar]
- Griffin, M.R. Beauveria Bassiana, a Cotton Endophyte with Biocontrol Activity against Seedling Disease. Ph.D. Thesis, University of Tennessee, Knoxville, TN, USA, 2007. [Google Scholar]
- Ownley, B.H.; Griffin, M.R.; Klingeman, W.E.; Gwinn, K.D.; Moulton, J.K.; Pereira, R.M. Beauveria bassiana: Endophytic colonization and plant disease control. J. Invertebr. Pathol. 2008, 98, 267–270. [Google Scholar] [CrossRef]
- Vega, F.E. Insect pathology and fungal endophytes. J. Invertebr. Pathol. 2008, 98, 277–279. [Google Scholar] [CrossRef]
- Herre, E.A.; Mejía, L.C.; Kyllo, D.A.; Rojas, E.; Maynard, Z.; Butler, A.; Van Bael, S.A. Ecological implications of anti-pathogen effects of tropical fungal endophytes and mycorrhizae. Ecology 2007, 88, 550–558. [Google Scholar] [CrossRef]
- Card, S.; Johnson, L.; Teasdale, S.; Caradus, J. Deciphering endophyte behaviour: The link between endophyte biology and efficacious biological control agents. FEMS Microbiol. Ecol. 2016, 92. [Google Scholar] [CrossRef] [PubMed]
- Barra-Bucarei, L.; France, A.; Millas, P. Crossing frontiers: Endophytic entomopathogenic fungi for biological control of plant diseases. In Endophytes for a Growing World; Cambridge University Press: Cambridge, UK, 2019; p. 67. [Google Scholar]
- France, I.; Gerding, G.; Gerding, M.; Sandoval, A. Patogenicidad de una colección de cepas nativas de Metarhizium spp. y Beauveria spp. en Aegorhinus Superciliosus, Asynonychus Cervinus y Otiorhynchus Sulcatus. Agric. Técnica 2000, 60, 205–215. [Google Scholar] [CrossRef]
- Moore, D.; Bateman, R.P.; Carey, M.; Prior, C. Long-term storage of Metarhizium flavoviride conidia in oil formulations for the control of locusts and grasshoppers. Biocontrol Sci. Technol. 1995, 5, 193–200. [Google Scholar] [CrossRef]
- Resquín-Romero, G.; Garrido-Jurado, I.; Delso, C.; Ríos-Moreno, A.; Quesada-Moraga, E. Transient endophytic colonizations of plants improve the outcome of foliar applications of mycoinsecticides against chewing insects. J. Invertebr. Pathol. 2016, 136, 23–31. [Google Scholar] [CrossRef] [PubMed]
- Watanabe, T. Pictorial Atlas of Soil and Seed Fungi: Morphologies of Cultured Fungi and Key to Species; CRC press: Boca Raton, FL, USA, 2010. [Google Scholar]
- Hegedus, D.D.; Khachatourians, G.G. Identification and differentiation of the entomopathogenic fungus Beauveria bassiana using polymerase chain reaction and single-strand conformation polymorphism analysis. J. Invertebr. Pathol. 1996, 67, 289–299. [Google Scholar] [CrossRef]
- Anees, M.; Tronsmo, A.; Edel-Hermann, V.; Hjeljord, L.G.; Héraud, C.; Steinberg, C. Characterization of field isolates of trichoderma antagonistic against Rhizoctonia Solani. Fungal Biol. 2010, 114, 691–701. [Google Scholar] [CrossRef]
- Martin-Hernandez, A.M.; Dufresne, M.; Hugouvieux, V.; Melton, R.; Osbourn, A. Effects of targeted replacement of the tomatinase gene on the interaction of Septoria lycopersici with tomato plants. Mol. Plant-Microbe Interact. 2000, 13, 1301–1311. [Google Scholar] [CrossRef]
- Kim, J.-C.; Choi, G.J.; Park, J.-H.; Kim, H.T.; Cho, K.Y. Activity against plant pathogenic fungi of phomalactone isolated from Nigrospora sphaerica. Pest Manag. Sci. Former. Pestic. Sci. 2001, 57, 554–559. [Google Scholar] [CrossRef]
- Rueden, C.; Dietz, C.; Horn, M.; Schindelin, J.; Northan, B.; Berthold, M.; Eliceiri, K. ImageJ Ops [Software]. Available online: http://imagej.net/Ops (accessed on 24 July 2017).
- Di Rienzo, J.A.; Casanoves, F.; Balzarini, M.G.; Gonzalez, L.; Tablada, M.; Robledo, C.W. Info Stat Versión 2011. Grupo InfoStat, FCA, Universidad Nacional de Córdoba, Argentina. Available online: http://www.infostat.com.ar (accessed on 26 September 2018).
- Powell, W.A.; Klingeman, W.E.; Ownley, B.H.; Gwinn, K.D. Evidence of endophytic Beauveria bassiana in seed-treated tomato plants acting as a systemic entomopathogen to larval Helicoverpa zea (Lepidoptera: Noctuidae). J. Entomol. Sci. 2009, 44, 391–396. [Google Scholar] [CrossRef]
- Paul, N.C.; Deng, J.X.; Sang, H.-K.; Choi, Y.-P.; Yu, S.-H. Distribution and antifungal activity of endophytic fungi in different growth stages of chili pepper (Capsicum annuum L.) in Korea. Plant Pathol. J. 2012, 28, 10–19. [Google Scholar] [CrossRef]
- Hernawati, H.; Wiyono, S.; Santoso, S. Leaf endophytic fungi of chili (Capsicum annuum) and their role in the protection against Aphis gossypii (Homoptera: Aphididae). Biodiversitas J. Biol. Divers. 2011, 12. [Google Scholar] [CrossRef]
- Jaber, L.R.; Araj, S.-E. Interactions among endophytic fungal entomopathogens (Ascomycota: Hypocreales), the green peach aphid Myzus persicae Sulzer (Homoptera: Aphididae), and the aphid endoparasitoid Aphidius colemani Viereck (Hymenoptera: Braconidae). Biol. Control 2018, 116, 53–61. [Google Scholar] [CrossRef]
- Klieber, J.; Reineke, A. The entomopathogen Beauveria bassiana has epiphytic and endophytic activity against the tomato leaf miner Tuta absoluta. J. Appl. Entomol. 2016, 140, 580–589. [Google Scholar] [CrossRef]
- Quesada-Moraga, E.; Landa, B.B.; Muñoz-Ledesma, J.; Jiménez-Diáz, R.M.; Santiago-Alvarez, C. Endophytic colonization of Opium poppy, Papaver somniferum, by an entomopathogenic Beauveria bassiana strain. Mycopathologia 2006, 161, 323–329. [Google Scholar] [CrossRef]
- Akello, J.; Dubois, T.; Gold, C.S.; Coyne, D.; Nakavuma, J.; Paparu, P. Beauveria bassiana (Balsamo) Vuillemin as an endophyte in tissue culture banana (Musa spp.). J. Invertebr. Pathol. 2007, 96, 34–42. [Google Scholar] [CrossRef]
- Tefera, T.; Vidal, S. Effect of Inoculation Method and Plant Growth Medium on Endophytic Colonization of Sorghum by the Entomopathogenic Fungus Beauveria bassiana. BioControl 2009, 54, 663–669. [Google Scholar] [CrossRef]
- Jaber, L.R.; Ownley, B.H. Can we use entomopathogenic fungi as endophytes for dual biological control of insect pests and plant pathogens? Biol. Control 2018, 116, 36–45. [Google Scholar] [CrossRef]
- Wraight, S.P.; Carruthers, R.I.; Jaronski, S.T.; Bradley, C.A.; Garza, C.J.; Galaini-Wraight, S. Evaluation of the entomopathogenic fungi Beauveria bassiana and Paecilomyces fumosoroseus for microbial control of the silverleaf whitefly, Bemisia argentifolii. Biol. Control 2000, 17, 203–217. [Google Scholar] [CrossRef]
- Jaber, L.R.; Enkerli, J. Effect of seed treatment duration on growth and colonization of Vicia faba by endophytic Beauveria bassiana and Metarhizium brunneum. Biol. Control 2016, 103, 187–195. [Google Scholar] [CrossRef]
- Behie, S.W.; Jones, S.J.; Bidochka, M.J. Plant tissue localization of the endophytic insect pathogenic fungi Metarhizium and Beauveria. Fungal Ecol. 2015, 13, 112–119. [Google Scholar] [CrossRef]
- Barelli, L.; Moonjely, S.; Behie, S.W.; Bidochka, M.J. Fungi with multifunctional lifestyles: Endophytic insect pathogenic fungi. Plant Mol. Biol. 2016, 90, 657–664. [Google Scholar] [CrossRef] [PubMed]
- Behie, S.W.; Zelisko, P.M.; Bidochka, M.J. Endophytic insect-parasitic fungi translocate nitrogen directly from insects to plants. Science 2012, 336, 1576–1577. [Google Scholar] [CrossRef] [PubMed]
- Parsa, S.; Ortiz, V.; Gómez-Jiménez, M.I.; Kramer, M.; Vega, F.E. Root environment is a key determinant of fungal entomopathogen endophytism following seed treatment in the common bean, Phaseolus vulgaris. Biol. Control 2018, 116, 74–81. [Google Scholar] [CrossRef] [PubMed]
- Keller, S.; Zimmermann, G.; Wilding, N.; Collins, N.M.; Hammond, P.M.; Webber, J.F. Mycopathogens of soil insects. In Insect-Fungus Interactions; Academic Press: London, UK, 1989; pp. 239–270. [Google Scholar]
- Hajek, A.E. Ecology of terrestrial fungal entomopathogens. In Advances in Microbial Ecology; Springer: Berlin/Heidelberg, Germany, 1997; pp. 193–249. [Google Scholar]
- Feng, N.-X.; Yu, J.; Zhao, H.-M.; Cheng, Y.-T.; Mo, C.-H.; Cai, Q.-Y.; Li, Y.-W.; Li, H.; Wong, M.-H. Efficient phytoremediation of organic contaminants in soils using plant–endophyte partnerships. Sci. Total Environ. 2017, 583, 352–368. [Google Scholar] [CrossRef]
- Meyling, N.V.; Eilenberg, J. Ecology of the entomopathogenic fungi Beauveria bassiana and Metarhizium anisopliae in temperate agroecosystems: Potential for conservation biological control. Biol. Control 2007, 43, 145–155. [Google Scholar] [CrossRef]
- Wagner, B.L.; Lewis, L.C. Colonization of corn, Zea mays, by the entomopathogenic fungus Beauveria bassiana. Appl. Environ. Microbiol. 2000, 66, 3468–3473. [Google Scholar] [CrossRef]
- Parine, N.R.; Pathan, A.K.; Sarayu, B.; Nishanth, V.S.; Bobbarala, V. Antibacterial efficacy of secondary metabolites from entomopathogenic fungi Beauveria bassiana. Int. J. Chem. Anal. Sci. 2010, 1, 94–96. [Google Scholar]
- Vining, L.C.; Kelleher, W.J.; Schwarting, A.E. Oosporein production by a strain of Beauveria bassiana originally identified as Amanita muscaria. Can. J. Microbiol. 1962, 8, 931–933. [Google Scholar] [CrossRef]
- Hamill, R.L.; Higgens, C.E.; Boaz, H.E.; Gorman, M. The structure op beauvericin, a new depsipeptide antibiotic toxic to Artemia salina. Tetrahedron Lett. 1969, 10, 4255–4258. [Google Scholar] [CrossRef]
- Suzuki, A.; Kanaoka, M.; Isogai, A.; Tamura, S.; Murakoshi, S.; Ichinoe, M. Bassianolide, a new insecticidal cyclodepsipeptide from Beauveria bassiana and Verticillium lecanii. Tetrahedron Lett. 1977, 18, 2167–2170. [Google Scholar] [CrossRef]
- Logrieco, A.; Moretti, A.; Castella, G.; Kostecki, M.; Golinski, P.; Ritieni, A.; Chelkowski, J. Beauvericin production by Fusarium species. Appl. Environ. Microbiol. 1998, 64, 3084–3088. [Google Scholar] [CrossRef] [PubMed]
- Nagaoka, T.; Nakata, K.; Kouno, K. Antifungal activity of oosporein from an antagonistic fungus against Phytophthora infestans. Z. Naturforschung C 2004, 59, 302–304. [Google Scholar] [CrossRef] [PubMed][Green Version]
- Wang, Q.; Xu, L. Beauvericin, a bioactive compound produced by fungi: A short review. Molecules 2012, 17, 2367–2377. [Google Scholar] [CrossRef] [PubMed]
- Feng, P.; Shang, Y.; Cen, K.; Wang, C. Fungal biosynthesis of the bibenzoquinone oosporein to evade insect immunity. Proc. Natl. Acad. Sci. USA 2015, 112, 11365–11370. [Google Scholar] [CrossRef]
- Orole, O.O.; Adejumo, T.O. Activity of fungal endophytes against four maize wilt pathogens. Afr. J. Microbiol. Res. 2009, 3, 969–973. [Google Scholar]
- Bark, Y.G.; Lee, D.G.; Kang, S.C.; Kim, Y.H. Antibiotic properties of an entomopathogenic fungus, Beauveria bassiana, on Fusarium oxysporum and Botrytis cinerea. Korean J. Plant Pathol. 1996, 12, 245–250. [Google Scholar]
- Renwick, A.; Campbell, R.; Coe, S. Assessment of in vivo screening systems for potential biocontrol agents of Gaeumannomyces graminis. Plant Pathol. 1991, 40, 524–532. [Google Scholar] [CrossRef]
- Ownley, B.H.; Pereira, R.M.; Klingeman, W.E.; Quigley, N.B.; Leckie, B.M. Beauveria bassiana, a dual purpose biocontrol organism, with activity against insect pests and plant pathogens. In Emerging Concepts in Plant Health Management; Research Signpost: Thiruvananthapuram, India, 2004; pp. 255–269. [Google Scholar]
- Vega, F.E.; Goettel, M.S.; Blackwell, M.; Chandler, D.; Jackson, M.A.; Keller, S.; Koike, M.; Maniania, N.K.; Monzon, A.; Ownley, B.H. Fungal entomopathogens: New insights on their ecology. Fungal Ecol. 2009, 2, 149–159. [Google Scholar] [CrossRef]
- Jaber, L.R. Grapevine leaf tissue colonization by the fungal entomopathogen Beauveria bassiana. L. and its effect against downy mildew. BioControl 2015, 60, 103–112. [Google Scholar] [CrossRef]
- El Kichaoui, A.; Elnabris, K.; Shafie, A.; Fayyad, N.; Arafa, M.; El Hindi, M. Development of Beauveria bassiana based bio-fungicide against Fusarium wilt pathogens for Capsicum annuum, a promising approach toward vital biocontrol industry in Gaza strip. IUG J. Nat. Stud. 2017, 25, 183–190. [Google Scholar]
- Jaber, L.R.; Salem, N. Endophytic colonization of squash by the fungal entomopathogen Beauveria bassiana (Ascomycota: Hypocreales) for managing Zucchini Yellow Mosaic Virus in cucurbits. Biocontrol Sci. Technol. 2014, 24, 1096–1109. [Google Scholar] [CrossRef]

| Code Strain * | Species | Collection Location | Origin |
|---|---|---|---|
| RGM 393 | Beauveriabassiana | Robinson Crusoe, Valparaíso Region, Chile. | Native forest soil |
| RGM 461 | Beauveriabassiana | Cañete, Biobío Region, Chile. | Natural pasture soil |
| RGM 547 | Beauveriabassiana | Santa Bárbara, Biobío Region, Chile. | Natural pasture soil |
| RGM 557 | Beauveriabassiana | Los Lagos, Los Lagos Region, Chile. | Natural pasture soil |
| RGM 565 | Beauveriabassiana | Portezuelo, Biobío Region, Chile. | Natural pasture soil |
| RGM 570 | Beauveriabassiana | Molina, Maule Region, Chile. | Arable soil, Vitis vinifera fruit crop |
| RGM 632 | Beauveriabassiana | Pencahue, Maule Region, Chile. | Natural pasture soil |
| RGM 644 | Beauveriabassiana | Icalma, La Araucanía Region, Chile. | Natural pasture soil |
| RGM 657 | Beauveriabassiana | Puerto Ibañez, Aysén del General Carlos Ibáñez del Campo Region, Chile. | Natural pasture soil |
| RGM 731 | Beauveriabassiana | Río Cisnes, Aysén del General Carlos Ibáñez del Campo Region, Chile. | Natural pasture soil |
| RGM 2519 | Botrytis cinerea | Colín, Maule Region, Chile | Tomato plant |
| Species | Plant Part | Treatments | ||||||||||
|---|---|---|---|---|---|---|---|---|---|---|---|---|
| RGM 393 | RGM 461 | RGM 547 | RGM 557 | RGM 565 | RGM 570 | RGM 632 | RGM 644 | RGM 657 | RGM 731 | Control 1 | ||
| Chili pepper | Leaves | 0 2 ± 0.0 3 d 4 | 0 ± 0.0 d | 68 ± 13.6 a | 28 ± 13.6 bc | 36 ± 16.0 b | 36 ± 7.5 b | 10 ± 3,2 cd | 36 ± 7.5 b | 32 ± 8.0 bc | 52 ± 8.0 ab | 0 ± 0.0 d |
| Stems | 0 ± 0.0 b | 0 ± 0.0 b | 2 ± 2.0 b | 12 ± 2 a | 14 ± 2.5 a | 14 ± 2.5 a | 2 ± 2.0 b | 14 ± 4.0 a | 14 ± 2.5 a | 14 ± 2.5 a | 0 ± 0.0 b | |
| Roots | 0 ± 0.0 d | 0 ± 0.0 d | 34 ± 6.8 a | 18 ± 5.8 bc | 18 ± 8 bc | 18 ± 3.7 bc | 10 ± 3.2 cd | 16 ± 5.1 bc | 24 ± 9.8 abc | 28 ± 3.7 ab | 0 ± 0.0 d | |
| Tomato | Leaves | 10 ± 6.3 ab | 10 ± 3.9 ab | 34 ± 17.2 ab | 48 ± 23.1 a | 24 ± 19.4 ab | 22 ± 11.8 ab | 20 ±12.3 ab | 24 ± 19.4 ab | 26 ± 3.7 ab | 18 ± 8.0 ab | 0 ± 0.0 b |
| Stems | 12 ± 8.0 abc | 36 ± 19.8 abc | 44 ± 21.1 ab | 38 ± 19.4 ab | 36 ± 16. abc | 46 ± 6.9 a | 12 ± 8.0 abc | 12 ± 8.0 abc | 8 ± 5.8 bc | 36 ± 6.0 abc | 0 ± 0.0 b | |
| Roots | 8 ± 4.9 b | 18 ± 11.9 ab | 24 ± 19.4 ab | 46 ± 22.3 a | 34 ± 17.2 ab | 16 ± 5.1 ab | 20 ± 12.3 ab | 28 ± 18.6 ab | 18 ± 9.7 ab | 8 ± 4.9 b | 0 ± 0.0 b | |
© 2019 by the authors. Licensee MDPI, Basel, Switzerland. This article is an open access article distributed under the terms and conditions of the Creative Commons Attribution (CC BY) license (http://creativecommons.org/licenses/by/4.0/).
Share and Cite
Barra-Bucarei, L.; France Iglesias, A.; Gerding González, M.; Silva Aguayo, G.; Carrasco-Fernández, J.; Castro, J.F.; Ortiz Campos, J. Antifungal Activity of Beauveria bassiana Endophyte against Botrytis cinerea in Two Solanaceae Crops. Microorganisms 2020, 8, 65. https://doi.org/10.3390/microorganisms8010065
Barra-Bucarei L, France Iglesias A, Gerding González M, Silva Aguayo G, Carrasco-Fernández J, Castro JF, Ortiz Campos J. Antifungal Activity of Beauveria bassiana Endophyte against Botrytis cinerea in Two Solanaceae Crops. Microorganisms. 2020; 8(1):65. https://doi.org/10.3390/microorganisms8010065
Chicago/Turabian StyleBarra-Bucarei, Lorena, Andrés France Iglesias, Macarena Gerding González, Gonzalo Silva Aguayo, Jorge Carrasco-Fernández, Jean Franco Castro, and Javiera Ortiz Campos. 2020. "Antifungal Activity of Beauveria bassiana Endophyte against Botrytis cinerea in Two Solanaceae Crops" Microorganisms 8, no. 1: 65. https://doi.org/10.3390/microorganisms8010065
APA StyleBarra-Bucarei, L., France Iglesias, A., Gerding González, M., Silva Aguayo, G., Carrasco-Fernández, J., Castro, J. F., & Ortiz Campos, J. (2020). Antifungal Activity of Beauveria bassiana Endophyte against Botrytis cinerea in Two Solanaceae Crops. Microorganisms, 8(1), 65. https://doi.org/10.3390/microorganisms8010065

